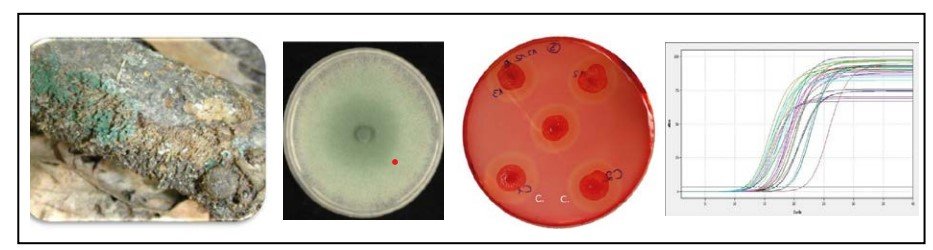

LV-Highlights
Bachelor-Kurse

Abbildung: (A) Micrococcus luteus in Reinkultur und auf einer Luftprobenplatte mit anderen Luftkeimen. (B) steriles Arbeiten: Beimpfen einer Agarplatte in der Sicherheitswerkbank (C) Bacillus subtilis unter dem Mikroskop nach der Gramfärbung (D) Fluoreszierende Bakterienkolonien (Pseudomonas sp.) aus einer Bodenprobe.
Das Pflichtmodul 15 besteht aus einer Vorlesung zur mikrobiellen Physiologie und einem Grundpraktikum zum mikrobiellen Labor.
Im Rahmen der Vorlesung werden Grundlagen der mikrobiellen Physiologie vermittelt. Studierende verstehen die bioenergetischen Grundlagen des Stoffwechsels sowie die Funktionalität von mikrobiellen Zellen und kennen die Vielfalt mikrobieller Lebensformen und Ernährungsweisen (z.B. aerobe und anaerobe Atmung, Gärung, Phototrophie, Lithotrophie, etc.). Die Studierenden lernen wie sich die physiologischen Eigenschaften in mikrobiellen Anpassungen an abiotische Rahmenbedingungen (Temperatur, pH-Wert, Sauerstoffversorgung) widerspiegeln und es Mikroorganismen somit möglich wird, sehr unterschiedliche, auch extreme Habitate zu besiedeln.
In den Laborübungen erwerben die Studierenden praktische Fertigkeiten in mikrobiologischen Arbeitsabläufen im Labor. Hierzu zählen generelle Sicherheitsmaßnahmen, das sterile Arbeiten in einer Sicherheitswerkbank, der sichere Umgang mit Mikroorganismen und auch Methoden zur Isolierung, Kultivierung und Quantifizierung von Mikroorganismen. Die Studierenden werden mit den Anforderungen an Nährmedien vertraut gemacht und sind in der Lage, diese eigenständig herzustellen.
Die Studierenden haben die Möglichkeit, Luftproben, verschiedene Oberflächen sowie mitgebrachte Boden- oder Wasserproben auf ihre Keimdichte zu untersuchen. Des Weiteren erfolgt eine Überprüfung des Wirkspektrums von Antibiotika, und durch die Herstellung von Joghurt erhalten die Teilnehmenden Einblicke in die Lebensmittelproduktion mit Mikroorganismen. Aus dem Bereich Molekularbiologie/Gentechnik wird mit E. coli ein Experiment zur bakteriellen Transformation durchgeführt und damit die Genregulation bei Prokaryoten untersucht. Transformiert wird das Gen, welches für das grün fluoreszierende Protein (GFP) codiert.
In diesem fortgeschrittenen Modul geht es um die eigenständige Planung und Durchführung wesentlicher mikrobiologischer Methoden, die sowohl in der Forschung als auch in der Industrie unverzichtbar sind (z.B. in den Bereichen Lebensmittelindustrie, Biotechnologie, Pharmazie und Umweltanalytik). Die Vorlesung vermittelt die theoretischen Hintergründe, während im Praktikum verschiedene Versuche zur Physiologie von Mikroorganismen (Bakterien und Pilze) im Rahmen von Gruppenarbeiten durchgeführt werden. Dazu zählen steriles Arbeiten, Kultivierung bei unterschiedlichen Bedingungen mit verschiedenen Zielen, Quantifizierung und Abtötung von Mikroorganismen, sowie molekularbiologische Charakterisierung von Isolaten.
Dieses Modul wird für das Masterstudium Mikrobiologie nachdrücklich empfohlen. Seid dabei!

In dem Modul werden die wesentlichen mikrobiologischen Prozesse von mikrobiellen Brennstoffzellen (MFCs) vermittelt. Wir vertiefen die Kenntnisse in der Laborpraxis, insbesondere im richtigen Umgang mit Umweltproben, DNA-Extraktionen, PCR und dem Aufbau von MFCs.
Inhalt:
- Bau von mikrobiellen Brennstoffzellen (MFCs)
- DNA-Extraktionen und PCR
- Untersuchung der mikrobiellen Gemeinschaften mit Hilfe grundlegender Bioinformatik
- Messung der erzeugten Elektrizität
Zum Abschluss diskutieren wir Optimierungen und biotechnologische Anwendungen von MFCs.

In diesem Wahlmodul wird die Bedeutung und Vielfalt von Mikroorganismen in der Umwelt und deren Einfluss auf und beeinflussung durch den Klimawandel behandelt. Das Modul besteht aus einer Vorlesung, einem Exkursionsteil und einem Laborteil. Inhalte der theoretischen und praktischen Einheiten sind unter anderem:
- Die Vielfalt von Mikroorganismen in unserer Umwelt und wie man sie erkennt (z.B. Pilze, Phytopathogene, Bakterien)
- Probenahme und Probenaufarbeitung von Umweltproben um Mikroorganismen mithilfe unterschiedlicher Methoden nachzuweisen (z.B. Luftproben, Wasserproben, Bodenproben, Prokaryonten und Eukaryonten).
- Biotechnologisches Potential von Mikroorganismen im Zusammenhang mit ressourcen-schonenden Produktionsprozessen (z.B. Medikamente, Rohstoffe aus Mikroorganismen, „Novel Foods“ aus Mikroorganismen).
- Mikroorganismen und globale Stoffkreisläufe (z.B. Recycling, carbon sink, Methanproduktion, One Health)
Das Hauptziel dieser Lehrveranstaltung besteht darin, den Studierenden ein Bewusstsein für die Vielfalt der Mikroorganismen in unserer Umwelt zu vermitteln. Dabei werden zusätzlich relevante Umweltparameter berücksichtigt, wie beispielsweise der Bodentyp, die Bewirtschaftungsform und die anthropogene Beeinflussung. In praktischen Übungen im Labor erfahren die Studierenden außerdem, wie diese Proben verarbeitet werden.

Master-Kurse
Dieses Modul ist als Arbeitsgemeinschaft (AG) konzipiert und lehnt sich inhaltlich an aktuelle, wissenschaftliche Fragestellungen an. Ausgehend von einer grundlegenden theoretischen Einarbeitung in das Thema „anaerobe Mikroorganismen und deren Physiologie“ gehen wir Fragen nach wie: Wie ist „anaerob“ überhaupt definiert? Wie laufen Redox-Reaktionen ab? Warum explodieren Mikroorganismen nicht?
Wir beleuchten, ob Atmung auch ohne Sauerstoff möglich ist und klären den Unterschied zwischen Atmung und Gärung. Im praktischen Teil werden verschiedene Gruppen von anaeroben Mikroorganismen kultiviert und das Arbeiten mit strikt anaeroben (methanogenen) Reinkulturen erlernt.
Im Zuge eines Mischkulturversuches messen wir die Methanproduktion mittels GC, ein an der Methanogenese beteiligter Co-Faktor wird extrahiert und via HPLC der Länge nach aufgetrennt (analysiert) und die mikrobielle Gemeinschaft mit molekularbiologischen Methoden charakterisiert.

In enger Anlehnung an aktuelle Forschungsfragen (forschungsgeleitete Lehre) wird in diesem Modul das Wachstum und die Primär- bzw. Sekundärmetabolitenproduktion von filamentösen Pilzen in Bioreaktor-Batchkulturen sowie anderen (selbst gewählten) Kultivierungsformen und - bedingungen (z.B. Co-Kultivierung, Variationen in Belichtungsbedingungen, Mediumskomposition) analysiert. Von zentralem Interesse sind Sekundärmetabolite, welche auch als Photosensitizer dienen und potenziell in alternativen Therapieansätzen (Photodynamische Therapie) gegen multiresistente Mikroorganismen sowie als Antikrebsmittel eingesetzt werden könnten. Die bislang noch kaum untersuchten Kultivierungsbedingungen, die zur Produktion dieser pharmakologisch interessanten Verbindungen führen, sind konkreter Forschungsgegenstand dieses Moduls.

(a) Photobioreaktor, (b) Bioreaktorkultivierung mit Xanthoepocinproduktion (Gelbfärbung) im Verlauf einer Woche, (c) Kulturfärbung von Bioreaktor-Batchkulturen in Abhängigkeit von den Belichtungsbedingungen während der Kultivierung, (d) Gutationstropfenbildung bei Co-Kultivierung auf Petrischalen (Photomaterial von J. Winkler, F. Burgstaller, J. Metzlaff und M. Meitinger).
In diesem Modul lernen die Studierenden Methoden zur genetischen Manipulation von Bakterien und Pilzen einzusetzen. Sie stellen mittels Rekombinationsklonierung aus PCR-amplifizierten Fragmenten ein GFP-kodierendes Expressionsplasmid her und vermehren dieses in Escherichia coli. Nach der Plasmidisolierung aus den Bakterienzellen wird das Plasmid verifiziert und zur genetischen Manipulation des mykoparasitischen Schimmelpilzes Trichoderma atroviride verwendet. Während der Transformation wird die Lokus-spezifische Integration der GFP-Expressionskassette in das Pilzgenom durch die CRISPR-Cas Genschere unterstützt. Die erhaltenen Pilztransformanten werden abschliessend genotypisiert und phänotypisch mittels Life cell Imaging charakterisiert. Im begleitenden Seminar werden mittels von den Studierenden erstellter Vorträge die Kenntnisse über den wissenschaftlichen Hintergrund und die angewendeten Methoden vertieft und in der Gruppe diskutiert.
In this module, students learn to apply methods for the genetic manipulation of bacteria and fungi. Using recombinational cloning, they produce a GFP-encoding expression plasmid from PCR-amplified fragments and propagate it in Escherichia coli. After plasmid isolation from the bacterial cells, the plasmid is verified and used for genetic manipulation of the mycoparasitic mold Trichoderma atroviride. During transformation, the locus-specific integration of the GFP expression cassette into the fungal genome is supported by CRISPR-Cas genetic engineering. Finally, the resulting fungal transformants will be genotyped and phenotypically characterized by life cell imaging. In the accompanying seminar, the knowledge of the scientific background and the methods used will be deepened and discussed in the group by means of presentations prepared by the students.

Wer über das Klima spricht, muss auch über Mikroorganismen sprechen
Modul Bodenmikrobiologie & Klimawandel – Masterstudium Mikrobiologie
Im Modul Bodenmikrobiologie & Klimawandel (Übung UE 718550 und Arbeitsgemeinschaft AG 718549) werden aktuelle Themen der Bodenmikrobiologie behandelt – von Ursachen und Folgen des Klimawandels über den Einsatz von Glyphosat bis hin zur Bodenentstehung im Gletschervorfeld.
Im Praktikum werden entsprechende Fragestellungen eigenständig untersucht und Ergebnisse statistisch ausgewertet und interpretiert.
Außerdem werden den Studierenden in diesem Modul zahlreiche Methoden theoretisch und praktisch vermittelt, u.a.:
- Erfassung von Aktivität und Abundanz von Mikroorganismen (u. a. Fluoreszenzmikroskopie,GC-Messungen, Enzymaktivitäten)
- Durchführung molekularbiologischer Untersuchungen zur Abundanz, Diversität undAktivität von Mikroorganismen (DNA-Extraktion, Droplet-digital PCR, Amplicon-Sequenzierung)
- Entnahme von Gas- und Bodenproben im Freiland
- Analyse der Gaszusammensetzung mittels Gaschromatographie
- Bestimmung bodenphysikalischer und bodenchemischer Parameter

Die Studierenden befassen sich in diesem Modul mit dem industriell relevanten und zur Produktion von Cellulose-abbauenden Enzymen eingesetzten Schimmelpilz Trichoderma reesei. Sie lernen die wichtigsten Enzymsysteme für den Celluloseabbau und deren Substrat-abhängige Regulation kennen und erfahren, wie der Pilz die Anwesenheit des Biopolymers erkennt und darauf reagiert. In Kleingruppen untersuchen die Studierenden im Labor den ihnen zugeteilten Stamm auf verschiedenen Ebenen (Genotyp, Genexpression, Enzymaktivität, Metabolom) und lernen dabei neben der Kultivierung auch das Arbeiten mit verschiedenen Biomolekülen (DNA, RNA, Proteine, Metaboliten) und Methoden zu deren Untersuchung. Im begleitenden Seminar werden mittels von den Studierenden erstellter Vorträge die Kenntnisse über den wissenschaftlichen Hintergrund und die angewendeten Methoden vertieft und in der Gruppe diskutiert.
In this module, students deal with the industrially relevant mold Trichoderma reesei, which is used for the production of cellulose-degrading enzymes. They get to know the most important enzyme systems for cellulose degradation and their substrate-dependent regulation and learn how the fungus recognizes the presence of the biopolymer and reacts to it. In small groups, the students examine the strain assigned to them in the laboratory at various levels (genotype, gene expression, enzyme activity, metabolome) and, in addition to cultivation, learn how to work with various biomolecules (DNA, RNA, proteins, metabolites) and methods for their analysis. In the accompanying seminar, knowledge of the scientific background and the methods used is deepened and discussed in the group by means of presentations prepared by the students.